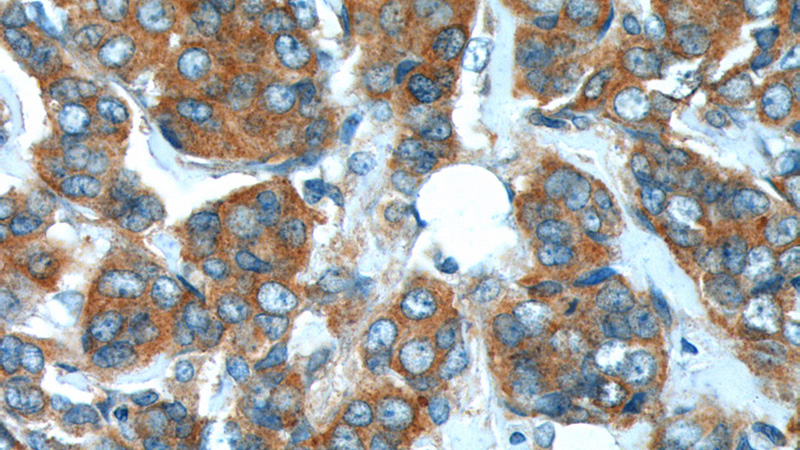
Immunohistochemistry of paraffin-embedded human breast cancer tissue slide using Catalog No:115469(SNX1 Antibody) at dilution of 1:200 (under 40x lens).

-
Product Name
SNX1 antibody
- Documents
-
Description
SNX1 Rabbit Polyclonal antibody. Positive WB detected in HeLa cells, Jurkat cells. Positive IP detected in HeLa cells. Positive IHC detected in human breast cancer tissue, human kidney tissue, human pancreas cancer tissue. Observed molecular weight by Western-blot: 59-70 kDa
-
Tested applications
ELISA, WB, IP, IHC
-
Species reactivity
Human,Mouse,Rat; other species not tested.
-
Alternative names
HsT17379 antibody; SNX1 antibody; SNX1A antibody; sorting nexin 1 antibody; Vps5 antibody
-
Isotype
Rabbit IgG
-
Preparation
This antibody was obtained by immunization of SNX1 recombinant protein (Accession Number: NM_003099). Purification method: Antigen affinity purified.
-
Clonality
Polyclonal
-
Formulation
PBS with 0.1% sodium azide and 50% glycerol pH 7.3.
-
Storage instructions
Store at -20℃. DO NOT ALIQUOT
-
Applications
Recommended Dilution:
WB: 1:500-1:5000
IP: 1:200-1:2000
IHC: 1:20-1:200
-
Validations

HeLa cells were subjected to SDS PAGE followed by western blot with Catalog No:115469(SNX1 antibody) at dilution of 1:1000
Immunohistochemistry of paraffin-embedded human breast cancer tissue slide using Catalog No:115469(SNX1 Antibody) at dilution of 1:200 (under 40x lens).

IP Result of anti-SNX1 (IP:Catalog No:115469, 4ug; Detection:Catalog No:115469 1:800) with HeLa cells lysate 2000ug.
-
Background
Sorting nexin 1 (SNX1, synonyms: SNX1A, MGC8664, HsT17379) is a member of the sorting nexin family. Members of this family contain a phox (PX) domain, which is a phosphoinositide binding domain, and are involved in intracellular trafficking. This endosomal protein regulates the cell-surface expression of epidermal growth factor receptor. SNX1 also has a role in sorting protease-activated receptor-1 from early endosomes to lysosomes. This protein may form oligomeric complexes with family members.
-
References
- Villar VA, Jones JE, Armando I. Sorting nexin 1 loss results in D5 dopamine receptor dysfunction in human renal proximal tubule cells and hypertension in mice. The Journal of biological chemistry. 288(1):152-63. 2013.
- Yamasaki T, Suzuki A, Hasebe R, Horiuchi M. Comparison of the anti-prion mechanism of four different anti-prion compounds, anti-PrP monoclonal antibody 44B1, pentosan polysulfate, chlorpromazine, and U18666A, in prion-infected mouse neuroblastoma cells. PloS one. 9(9):e106516. 2014.
- Jin J, Davis J, Zhu D. Identification of novel proteins affected by rotenone in mitochondria of dopaminergic cells. BMC neuroscience. 8:67. 2007.
- Gomez TS, Gorman JA, de Narvajas AA, Koenig AO, Billadeau DD. Trafficking defects in WASH-knockout fibroblasts originate from collapsed endosomal and lysosomal networks. Molecular biology of the cell. 23(16):3215-28. 2012.
Related Products / Services
Please note: All products are "FOR RESEARCH USE ONLY AND ARE NOT INTENDED FOR DIAGNOSTIC OR THERAPEUTIC USE"
